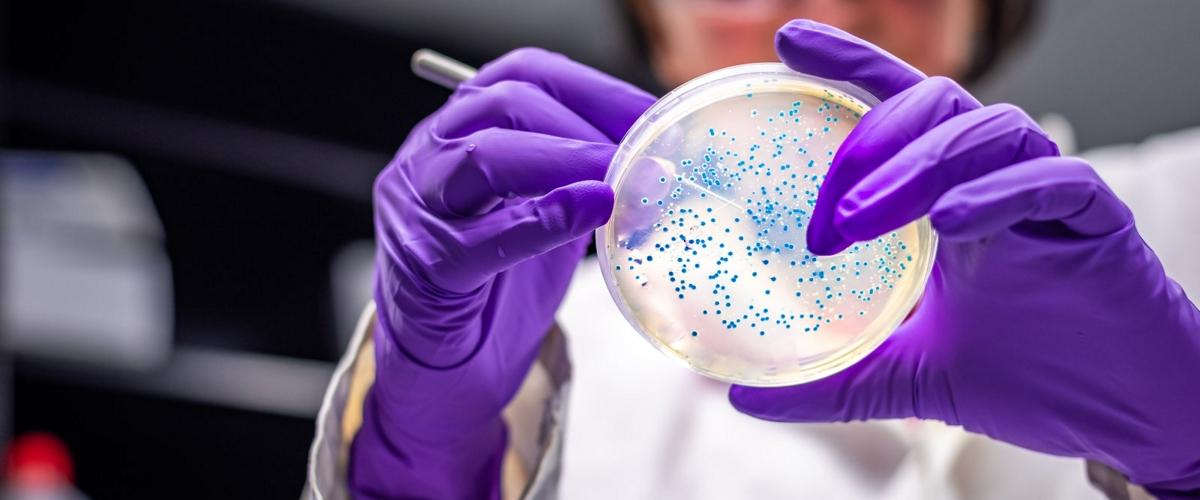
TODO:

Связь между микробиотой кишечника и диабетом в большинстве случаев изучается в сравнении здоровых людей с теми, кому уже было диагностировано это заболевание. Проблема такого подхода, как пишут ученые из Университета Гетеборга, в том, что сложно понять, как сильно болезнь или ее лечение повлияли на популяцию бактерий. Поэтому исследователи собрали свыше 1000 добровольцев с различными признаками преддиабета.
Преддиабет — предшествующее сахарному диабету состояние, характеризующееся нарушениями уровня глюкозы натощак и нарушениями толерантности к глюкозе. Однако эти аномалии еще недостаточно существенны, чтобы пациенту можно было поставить диагноз.
Шведские специалисты обнаружили определенные различия в микрофлоре кишечника между группой с преддиабетом и контрольной группой, пишет New Atlas. Лица с нарушениями уровня глюкозы натощак продемонстрировали меньшее разнообразие микробиоты, а пациенты с нарушениями толерантности к глюкозе обнаружили более заметные бактериальные изменения.
Также исследование показало, что у людей с преддиабетом и диабетом 2-го типа до начала лечения низкий уровень кишечных бактерий, вырабатывающих бутират, масляную кислоту. Прошлые работы указывают на снижение уровня этих бактерий в микробиоте диабетиков. Ученые делают вывод о связи между появлением симптомов диабета и снижением количества этих микроорганизмов.
Причинно-следственную связь между этими явлениями не установлена. Нужны дальнейшие исследования, чтобы понять, вызывают ли изменения микробиоты проблемы с метаболизмом или просто микробиота реагирует на метаболические нарушения.
«Наше исследование четко показало, что состав кишечной микробиоты может обладать большим потенциалом, помогая нам понять риски развития диабета 2-го типа и, как следствие, повысить наши шансы диагностировать, предотвратить и вылечить это заболевание», — заявил Фредрик Бекхед, руководитель научного проекта.
Диабет является ключевым фактором риска развития тяжелой формы COVID-19 и люди с таким заболеванием чаще умирают от осложнений коронавирусной инфекции. Однако судя по собранным австралийскими учеными клиническим данным, есть и обратная зависимость — COVID-19 может провоцировать у людей диабет 1-го типа.